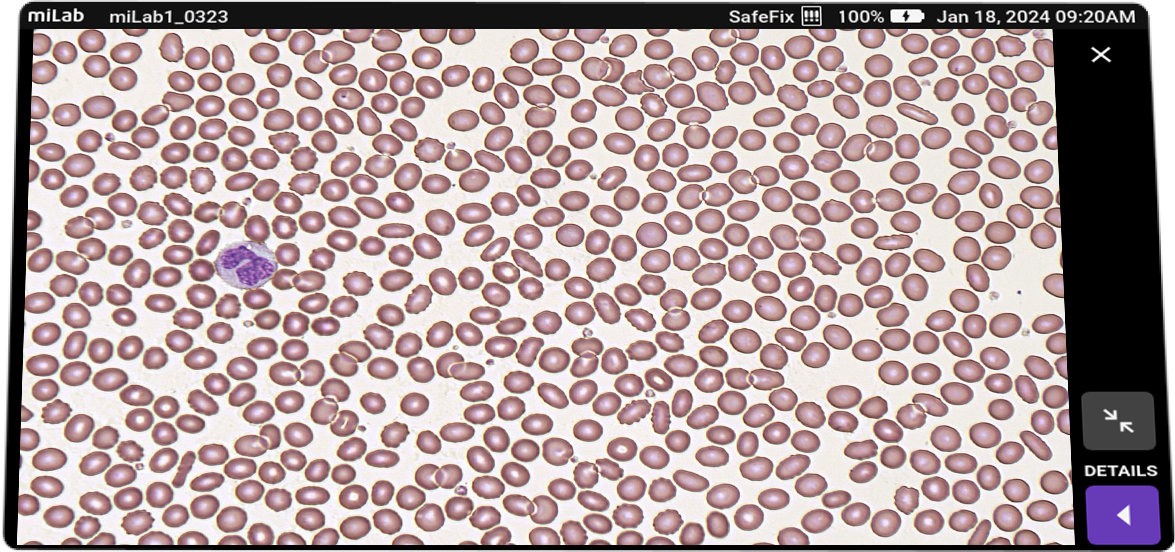

본 웹사이트는 사용자에게 최상의 사용자 경험을 제공하기 위해 쿠키를 사용합니다. 쿠키 정보는 브라우저에 저장되어 사용자가 당사 웹사이트로 돌아올 때 사용자를 인식하고, 사용자가 가장 흥미롭고 유용하다고 생각하는 웹사이트 섹션을 당사 팀이 파악하는 데 도움을 주는 등의 기능을 수행합니다.
CBC 및 세포형태분석 자동화 솔루션, miLab™ BCM
miLab™ BCM은 혈액 분석의 새로운 기준을 제시합니다. 전통적인 혈액 검사와 달리, 이 솔루션은 혈액 도말, 고정, 염색 등 샘플 프렙의 전 과정과 디지털이미징, AI 분석을 활용하여 전혈구검사(CBC) 및 혈구형태검사(Morphology Test)를 완전 자동화해 일관된 결과와 간편한 워크플로우를 제공합니다. 특히, 적은 검체량으로도 고품질의 세포 분석을 구현하여 최적화된 솔루션을 제공합니다.
miLab™ BCM은 기초 혈액검사의 접근성을 높이는 데 집중합니다.
혈액분석은 전세계에서 가장 많이 수행되는 진단 검사 중 하나지만,
여전히 부족한 인프라와 전문 인력의 한계로 인해 많은 사람들이 필수적인 검사조차 받기 어려운 현실입니다.
전세계 혈액분석 현황
* 2021년 기준
혈액검사 현황 및 기존 방식 한계
- 기본 혈액검사는 CBC 검사를 진행한 후, 결과에 이상이 있을 경우 추가적으로 혈구형태(Morphology)를 확인함
- 혈구형태검사 분석은 시약 준비, 혈액 도말, 염색, 세척, 이미지 분석 등 여러 단계로 이루어지며, 각 단계에서 높은 숙련도가 요구됨
- 각 단계별로 별도의 실험 공간과 다양한 장비 및 시약이 필요, 특히 중소 병원에서는 구현이 어려움
- 전문 진단 장비와 인프라 구축 및 유지 비용이 높아 농어촌이나 중저소득 국가에서는 도입이 제한적
- 대규모 실험실로 검체를 운송할 경우 높은 물류비용과 샘플 신선도 저하로 인해 추가적인 재검사가 발생
- 도심 지역으로 전문 인력이 집중되어 농어촌 및 의료 소외 지역에서는 전문 진단 인력 확보가 어려움
- 특히 COVID-19 이후 진단 수요가 급증하며 인력 편중 현상이 더욱 심화됨
- 혈구형태 검사의 경우 수작업 기반의 기존 검사 방식은 결과 품질이 인력의 숙련도에 따라 큰 차이를 보임
- 중저소득 국가에서는 검사 품질 관리와 교육 체계가 미흡하여 일관된 결과 확보가 어려움
혈액 도말과 염색부터 세포별 디지털이미지 확보와 AI 결과 분석까지,
이 모든 과정을 전자동으로
- (Integration) 혈액 검사 프로세스의 완전한 통합
- CBC와 Morphology 검사를 하나의 시스템에서 구현
- Morphology 검사는 고체 염색 기술을 적용해 염색, 세척, 건조 등 기존 복잡한 과정을 획기적으로 단순화
- 혈액 검사에 필요한 모든 시약과 도구를 스마트 카트리지로 대체하여 간편한 검사 환경 제공
- (Automation) 샘플 준비부터 AI 분석까지, CBC부터 Morphology 검사까지 완전 자동화
- 혈액 도말, 염색, 디지털 이미징, AI 기반 CBC·Morphology 분석을 한 장비로 자동 수행
- 자동 분석이 진행되는 동안, 의료 전문 인력은 다른 업무를 수행하며 효율성을 극대화
- (Classification) AI 기반 혈구 수치 및 형태 자동 분류
- AI 분석을 통해 CBC 주요 파라미터와 세포 형태별 사전 분류 결과 제공
- 디지털 이미지를 포함한 분석 데이터는 사용자 교육 및 훈련 자료로 활용 가능
- (Digitalization) 디지털 이미지 저장 및 원격 판독 지원
- 인터넷이 연결된 환경이라면 어디서든 miLab™ 플랫폼을 통해 검사 결과 판독 가능
- 진단 검사 인력이 부족한 지역에서도 도심 수준의 정밀한 진단 검사 접근성 확보
사용자의 실제 니즈에 따라
접근성 향상과
워크플로우 효율 개선을 위한
차별화된 가치를 제공합니다.
- 1. 자체적으로 혈액검사(CBC+Morphology)를 선별검사로서 수행하기 원하는 중소형 의료기관
- 타깃 고객
- CBC 장비를 보유하지 않았으나, 선별검사로서 CBC 및 Morphology 검사 수행을 계획하고 있는 중소형 의료기관 또는 병원 규모에 적합한 선별검사용 혈액검사 장비 도입을 원하는 의료기관
- 기대 가치
- CBC 및 Morphology 검사를 신규 검사로 추가하여 수익 항목 확대
- Background
- 일반혈액검사는 건강검진에 기본적으로 포함되어 있으며, 혈구성분(적혈구, 백혈구, 혈소판)의 개수와 크기, 분포 등의 특징을 분석, 빈혈이나 염증, 백혈병과 같은 여러 가지 골수 질환 정보를 알 수 있습니다.
- Problem
- 대형 병원과 달리, 중소형 의료기관은 혈액 검사 장비를 규모에 맞게 도입하지 못하거나, 아예 보유하지 않은 경우가 많습니다. 이에 따라 혈액 샘플을 대형 진단 검사실(laboratory)로 이송해야 하며, 이 과정에서 추가적인 비용이 발생할 뿐만 아니라, 샘플의 생체 활성이 저하된 상태에서 검사가 이루어질 가능성이 있습니다. 이는 진단의 정확성과 검사 효율성에 부정적인 영향을 미칠 수 있습니다.
- Use-Case
- 중소형 의료기관에 적합한 miLab™ 장비를 도입하면, 별도의 전문 인력 없이도 신속하고 정확한 CBC 및 Morphology 검사를 자체적으로 수행하여 선별검사를 진행할 수 있습니다. 이를 통해 혈액 검사의 접근성을 높이고, 검사 과정의 효율성을 향상시킬 수 있습니다.
- Benefits
- 지역 병·의원에서는 검사 서비스 제공을 통해 추가적인 수익을 창출할 수 있으며, 환자 입장에서도 가까운 의료기관에서 즉각적인 건강 상태 확인이 가능해져 의료 접근성이 크게 개선됩니다. 이는 조기 진단 및 치료로 이어질 가능성을 높이며, 전반적인 의료 서비스의 질을 향상시키는 데 기여할 수 있습니다.
- 2. 말초혈액도말검사의 생산성을 높이려는 의료기관
- 타깃 고객
- 말초혈액도말검사를 위한 진단검사실을 운영하고 있지만, 전문 인력의 노동집약적인 방식으로 검사를 수행하는 의료기관
- 기대 가치
- 말초혈액도말검사 자동화로 워크플로우 개선 및 생산성 향상
- Background
- 일반적인 말초혈액도말검사는 노동집약적인 방식으로 검사가 수행됩니다. 샘플 프렙 단계에서는 혈액 도말, 고정, 염색, 세척, 건조 등 과정을 수작업으로 진행하며, 현미경 분석 단계에서는 전문 인력이 현미경을 통해 혈구 세포의 형태와 분포를 하나씩 눈으로 확인하는 방식으로 진행됩니다.
- Problem
- 노동집약적인 방식으로 인해 말초혈액도말검사의 검사 건수가 증가할수록 전문 인력이 느끼는 육체적 피로감은 증가하게 됩니다. 전문 인력의 육체적 피로감이 증가할수록, 실수 등 휴먼에러 발생 가능성 역시 높아지게 됩니다. 또한, 의료기관마다 말초혈액도말검사를 위한 작업 표준이 고정되어 있기 때문에, 정해진 인원과 시간으로 보다 많은 검사를 수행하기는 어려운 상황입니다.
- Use-Case
- 말초혈액도말검사의 생산성 향상을 기대하는 의료기관에서는 miLab™ BCM을 도입해 전문 인력이 수행하던 작업을 일부 혹은 전체를 자동화할 수 있습니다. miLab™ BCM은 샘플 프렙부터 AI 기반 사전 혈구세포 분류까지 모든 과정을 자동으로 수행합니다. 따라서 전문 인력은 일일이 혈구 세포를 현미경으로 찾을 필요 없이, 모니터 화면을 통해 분석된 결과를 검토하고 최종 확인하는 역할에 집중할 수 있게 됩니다. 또한, 전문 인력이 근무하지 않는 야간/주말 시간에도 miLab™ BCM을 통한 자동 분석이 가능하고, 해당 분석 결과는 데이터베이스에 축적할 수 있습니다. 전문 인력은 다음날 출근하여 효율적으로 분석 결과를 검토하고 최종 확인할 수 있습니다.
- Benefits
- 해당 유형의 고객들은 miLab™ BCM 도입으로 정해진 인원과 시간으로 기존 대비 획기적으로 검사 수행 건수를 증가시킬 수 있습니다. 말초혈액도말검사에 대한 수요가 증가하는 의료기관에서는 전문 인력의 추가 고용 없이도 miLab™ BCM 도입으로 증가하는 검사 수요에 대응할 수 있습니다. 이같은 생산성 향상의 가치는 전문 인력의 인건비가 높은 고소득 국가에서 더 높습니다.
- 3. 말초혈액도말검사의 정확도를 높이고자 하는 의료기관
- 타깃 고객
- 전문 인력의 노동집약적인 방식으로 말초혈액도말검사 수행하고 있지만, 고용된 전문 인력의 숙련도가 낮은 의료기관
- 기대 가치
- 품질 보증 및 품질 관리 체계 강화로 말초혈액도말검사의 신뢰도 향상
- Background
- 일반적으로 말초혈액도말검사를 수행하는 전문 인력은 국가 차원에서 전문 의료인으로서 전문화된 지식과 풍부한 경험을 갖추도록 요구합니다. 대학 이상의 전문 교육 이수와 국가 자격시험 통과는 물론이고, 정기적인 실무 교육/훈련을 받도록 하고 있습니다. 한국 등 의료교육 시설 및 체계가 잘 갖춰진 국가에서는 전문 인력의 수준이 높게 유지되고 있으나, 중저소득국가에서는 의료교육 시설 및 체계가 충분하지 못한 상황입니다.
- Problem
- 말초혈액도말검사는 노동집약적인 방식으로 수행되기 때문에 전문 인력의 숙련도에 따라 분석 및 판단 결과에서 편차가 크게 나타납니다. 말초혈액도말검사의 분석 결과가 잘못될 경우에는 환자에 대한 잘못된 진단과 치료로 이어지게 됩니다. 의료기관은 고용된 인력이 정확한 분석 결과를 제공하고 있는지를 확인하기 위해서, 여러 전문 인력이 동시에 검사를 수행하도록 하여 그 결과를 비교해 보거나, 검증된 전문 인력이 해당 분석 결과를 검증하도록 할 수 있습니다. 그렇지만 이같은 방법은 모두 전문 인력 고용을 더 확대하거나, 전문성이 검증된 인력을 고용하는 등 추가적인 비용 부담이 발생하게 됩니다.
- Use-Case
- 말초혈액도말검사에 대한 정확도를 높이고자 하는 의료기관에서는 miLab™ BCM을 품질 관리 체계에 포함할 수 있습니다. miLab™ BCM은 샘플 프렙부터 AI 분석까지 말초혈액도말검사의 모든 과정을 표준화하였기 때문에 일관된 분석 결과를 제공합니다. 따라서 전문 인력이 수행한 말초혈액도말검사 결과와 miLab™ BCM 결과를 비교함으로써 전문 인력의 검사 결과 신뢰도를 확인할 수 있습니다. 또한, 숙련도가 낮은 전문 인력에게는 miLab™ BCM에서 생성된 디지털데이터를 교육/훈련 자료로 활용할 수도 있습니다.
- Benefits
- 해당 고객은 miLab™ BCM 도입으로 말초혈액도말검사 품질 관리 체계를 강화하고, 이를 통해 기존 전문 인력의 검사 신뢰도를 검증할 수 있습니다. 또한, miLab™ BCM의 디지털데이터를 교육/훈련 자료로 활용하면서, 의료 교육 시설과 체계가 부족한 중저소득국 환경에서 판독 전문성을 강화할 수 있습니다.
- 4. 원격으로 혈액검사를 수행하고자 하는 의료기관
- 타깃 고객
- 자체 혈액검사 수행뿐만 아니라, 환자/검체 위탁도 불가능한 의료기관
- 기대 가치
- 기존 의료체계에서 소외된 환자들에 대한 의료접근성 강화
- Background
- COVID-19 이후로 의료업계에서도 원격진료, 원격근무 등 일하는 방식의 변화가 나타나고 있습니다. 진단검사실 전문 인력들도 원격근무 환경에 익숙해지면서, 진단검사실에 출근하는 대신 원격으로 판독하고 업무를 수행하는 비중이 점차 확대되고 있습니다. COVID-19 이전에도 물리적 접근이 어려운 도서산간 지역에서는 진단검사실을 갖춘 보건시설과 전문 인력이 부족했지만, 그 이후에는 해당 지역에서는 전문 인력 확보에 더 어려움을 겪고 있습니다.
- Problem
- 물리적 접근이 어려운 도서산간 지역에서는 진단검사실 인프라와 전문 인력의 부재로, 환자 발생 시 상당한 거리를 이동해야 하는 불편이 존재합니다. 그 과정에서 환자는 신속한 진단검사와 적절한 치료를 받지 못할 수 있습니다. 게다가 먼 거리 병원으로 이동하는 과정에서 시간의 기회비용과 비용 지출에 대한 부담 역시 존재합니다.
- Use-Case
- 도서산간 등 의료접근성이 제약된 지역의 의료기관에서는 miLab™ BCM 장비를 도입해 환자의 건강상태를 현장에서 확인하고, 원격에 위치한 전문 인력에게 디지털데이터 전송을 통해 정밀 검사를 요청하는 방식으로 활용할 수 있습니다.
- Benefits
- 해당 고객은 miLab™ BCM 도입으로 도서산간 등 물리적 접근이 제약된 지역에서 기초 진단검사에 대한 접근성을 향상시킬 수 있습니다. 이를 바탕으로 보다 정확한 환자 상태 분석 및 모니터링이 가능합니다.
- 5. 특수 사례 (Special Situation)
혈액검사는 환자의 건강상태를 확인하기 위한 가장 기초적인 진단검사입니다. 위에서 언급한 일반적인 고객 유형 외에도 다양한 상황 사례들에서의 제품 적용 가능성을 모색하고 있습니다.
특히 miLab™ BCM과 관련해서는 CBC 장비조차 사용하기 어려운 자원 제약 환경에서 기초 혈액검사가 필요한 상황이나, 정맥혈이 아닌 손끝 채혈만으로 혈액 분석을 수행해야 하는 영유아 대상 혈액검사 등, 노을이 아직 확인하지 못한 다양한 시장 기회가 존재할 것으로 예상됩니다.
이같은 특수한 사례에서 miLab™ BCM 사용에 대해 관심이 있으시면 연락주시기 바랍니다.
Detect the target cells
in 20 min.
- miLab™ BCM Specification
- Sample Preparation
Smear method Automated ideal zone smear Staining method Romanowsky Sample type Venous blood Sample volume 4μℓ
- Imaging
Focus Multi-focus images acquired (5 z stack layers)
- Analysis
CBC - WBC Count
- RBC Count
- Hemoglobin
- Hematocrit
- Platelet Count
- MCV/MCH/MCHC
Morphology Test - WBC 5-Differential (#/%, Neutrophils, Lymphocytes, Monocytes, Eosinophils, Basophils
- Immature Granulocytes (#/%, Myelocytes / Metamyelocytes / Promyelocytes)
- Blast (#/%, Myeloblasts / Monoblasts / Lymphoblasts)
- Reactive Lymphocyte (#/%)
- nRBC (#)
- PLT clumping (#)
- Smudge Cell (#)
- Viewing Functions (miLab™ and miLab Viewer™)
- User Result Confirmation
- Cell View (Cell differential, Cell Category Modification and images download)
- Field View
- Cell Reclassification (Available from miLab Viewer™)
- Report (Available from miLab Viewer™ in PDF and Print-Out)
- Cell Image download
- Total Test Time
Avg. 20 mins
- Product Code
Product Code miLab™ Platform DMLA miLab™ Cartridge BCM CBCA miLab Viewer™ SMVA SafeFix™ CSFA miLab™ Slide Case ASCA

miLab™ Platform은 Gold Standard 방식인 현미경 검사 및 진단 프로세스를 그대로 따르는 세계 유일의 진단 플랫폼입니다. 현미경 진단 방식은 테크니션 또는 의료진의 숙련도에 따라 샘플 준비 및 진단 결과의 편차가 크지만, miLab™은 이 모든 과정을 전자동화해 오류를 큰 폭으로 줄였습니다.
by Hans-Peter Beck
University of Basel, Swiss TPH